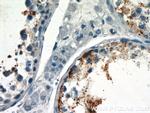
UBQLN3 Antibody in Immunohistochemistry (Paraffin) (IHC (P))

Search
Proteintech
UBQLN3 Polyclonal Antibody
{{$productOrderCtrl.translations['antibody.pdp.commerceCard.promotion.promotions']}}
{{$productOrderCtrl.translations['antibody.pdp.commerceCard.promotion.viewpromo']}}
{{$productOrderCtrl.translations['antibody.pdp.commerceCard.promotion.promocode']}}: {{promo.promoCode}} {{promo.promoTitle}} {{promo.promoDescription}}. {{$productOrderCtrl.translations['antibody.pdp.commerceCard.promotion.learnmore']}}
产品信息
23372-1-AP
种属反应
宿主/亚型
分类
类型
抗原
偶联物
形式
浓度
规格
纯化类型
保存液
内含物
保存条件
运输条件
产品详细信息
Immunogen sequence: WTSTHGGSG SRQGRQDGDQ DAPDIRNRFP NFLGIIRLYD YLQQLHENPQ SLGTYLQGTA SALSQSQEPP PSVNRVPPSS PSSQEPGSGQ PLPEESVAIK GRSSCPAFLR YPTENSTGQG GDQDGAGKSS TGHSTNLPDL VSGLGDSANR VPFAPLSFSP TAAIPGIPEP PWLPSPAYPR SLRPDGMNPA PQLQDEIQPQ LPLLMHLQAA MANPRALQAL RQIEQGLQVL ATEAPRLLLW FMPCLAGTGS VAGGIESRED PLMSEDPLPN PPPEVFPALD SAELGFLSPP FLHMLQDLVS TNPQQLQPEA HFQVQL (306-620 aa encoded by BC036743)
靶标信息
This gene encodes an ubiquitin-like protein (ubiquilin) that shares high degree of similarity with related products in yeast, rat and frog. Ubiquilins contain a N-terminal ubiquitin-like domain and a C-terminal ubiquitin-associated domain. They physically associate with both proteasomes and ubiquitin ligases, and thus thought to functionally link the ubiquitination machinery to the proteasome to affect in vivo protein degradation. This gene is specifically expressed in the testis, and proposed to regulate cell-cycle progression during spermatogenesis.
仅用于科研。不用于诊断过程。未经明确授权不得转售。
篇参考文献 (0)
生物信息学
蛋白别名: testicular tissue protein Li 220; TUP-1; Ubiquilin-3
基因别名: 4933400K24Rik; TUP-1; UBQLN3
UniProt ID: (Human) Q9H347, (Mouse) Q8C5U9
Entrez Gene ID: (Human) 50613, (Mouse) 244178